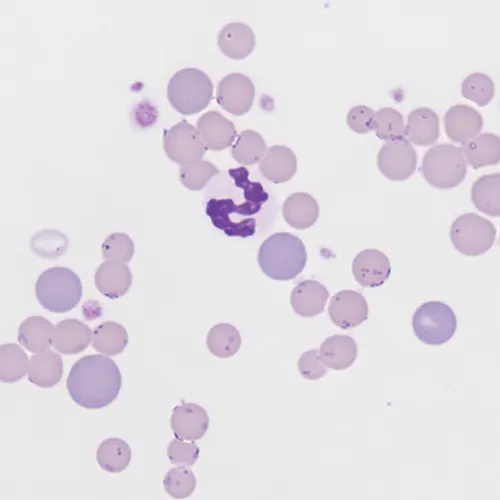

Hemotropic Mycoplasma spp
Edward B. Breitschwerdt, DVM, DACVIM (SAIM), North Carolina State University

Overview
Hemotropic Mycoplasma spp of the cat
M haemofelis
Candidatus M haemominutum
Candidatus M turicensis
Hemotropic Mycoplasma spp of the dog
M haemocanis
Candidatus M hematoparvum
Note: Experimental data are not available on the need or efficacy of treatment of hemotropic Mycoplasma spp infections in dogs.
Mycoplasma haemofelis. Photo courtesy of Jennifer Neel, DVM, DACVP (Clinical), North Carolina State University.
Pradofloxacin
Cats: 5 or 10 mg/kg PO once a day for 14 consecutive days1
Contraindicated in cats with hypersensitivity to quinolones2
Dogs (extralabel, based on anecdotal evidence): 5 or 10 mg/kg PO once or twice a day for 14 consecutive days
Although in some countries pradofloxacin is licensed for use in dogs, it is only available extralabel in the United States because of safety concerns (eg, marrow suppression with neutropenia/thrombocytopenia2).
Pradofloxacin, a fluoroquinolone antibiotic, disrupts bacterial replication by inhibiting DNA gyrase (thereby preventing DNA replication) and by blocking topoisomerase IV. In an experimental infection model in cats, pradofloxacin administered at 5 or 10 mg/kg showed efficacy similar to doxycycline against M haemofelis and appeared to provide more effective long-term clearance of M haemofelis organisms than did doxycycline administered at 5 mg/kg twice a day for 14 days.1
To date, there are no experimental data on treatment efficacy of pradofloxacin in dogs.
Marbofloxacin
Cats only: 2.75 mg/kg PO once a day for 14 days3-5
Marbofloxacin is a carboxylic acid–derivative fluoroquinolone antibiotic that disrupts bacterial replication by inhibiting DNA gyrase and thereby preventing DNA replication. Following experimental infection of cats with M haemofelis, marbofloxacin was safe and resulted in rapid hematologic improvement but did not consistently eliminate infection.3-5
Enrofloxacin
Cats: 5 mg/kg PO once a day6
Cats at risk for retinal lesions
Caution: 5 mg/kg is upper end of dosing for this indication, and because other efficacious and safer fluoroquinolones are available, pradofloxacin or marbofloxacin is recommended for treating hemotropic Mycoplasma spp infections in cats.
Dogs (based on anecdotal evidence): 5 or 10 mg/kg PO once a day for 14 days
Enrofloxacin, a fluoroquinolone antibiotic, disrupts bacterial replication by inhibiting DNA gyrase and thereby preventing DNA replication. Treatment with enrofloxacin at 5 mg/kg was well tolerated by cats and was equally or more effective than doxycycline administered at 5 mg/kg PO once a day for 14 days.6 However, enrofloxacin use in cats has been linked to a risk for retinal lesions.
No experimental data to date for treatment of hemotropic Mycoplasma spp infections in dogs
Doxycycline
Cats: 10 mg/kg PO twice a day for 14-28 days6
Neither a lower dose of 5 mg/kg twice a day nor higher dose of 10 mg/kg twice a day consistently eliminates Mycoplasma spp infections in cats.
Dogs (based on anecdotal evidence): 10 mg/kg PO once a day for 14-28 days7
Doxycycline is a tetracycline class antibiotic that inhibits protein synthesis by binding of aminoacyl-tRNA synthetase to the 30S ribosomal subunit in the mRNA translation complex. Historically, tetracycline derivatives were considered the drugs of choice for treating hemotropic Mycoplasma spp infections.
Based on laboratory studies, fluoroquinolones are of equal or superior efficacy for treating M haemofelis as compared with doxycycline. Administration of doxycycline rarely clears M haemofelis from the body and can be ineffective at controlling clinical signs of disease. In addition, oral administration of capsules has been associated with esophageal strictures in cats. Therefore, administration of a fluoroquinolone antibiotic has become the treatment of choice.6,8
No published data available for treatment of Mycoplasma spp infections in dogs
Minocycline
Cats (extralabel): 8.8 mg/kg PO once a day for 14 consecutive days9
Dogs (extralabel, based on anecdotal evidence): 10 mg/kg PO twice a day for 14 consecutive days
Minocycline is also in the tetracycline class of antibiotics. Recently, increased cost and decreased availability of doxycycline have sparked an interest in using minocycline as an alternative antibiotic in cats and dogs. However, there are no controlled studies involving the use of minocycline for treatment of hemotropic Mycoplasma spp infection (or any tick-borne disease) in cats or dogs.
Although gastrointestinal upset can occur in both dogs and cats, a recent pharmacokinetic study found that one 50-mg capsule PO once a day would provide appropriate dosing for most cats.9
Mycoplasma haemocanis organims. Long arrows point toward dot-like forms nestled in the membrane on the outer edge of the cell; shorter arrow points to a more ring-shaped M haemocanis organism. Photo courtesy of Jennifer Neel, DVM, DACVP (Clinical), North Carolina State University.

Prednisolone
Cats, Dogs: 1-2 mg/kg PO twice a day as needed to control secondary immune-mediated hemolysis10
Prednisolone is a synthetic glucocorticoid and a derivative of cortisol that is used to treat a variety of inflammatory and autoimmune conditions. Concurrent administration of immunosuppressive corticosteroids with an antibiotic is only recommended in cats and dogs with a rapidly progressive, severe hemolytic anemia. Because the cause of hemolysis is an infection, suppressing and hopefully eliminating the infection with an antibiotic is the primary objective. In some instances, hemolysis is so severe and rapidly progressive that the immune system must be suppressed to keep the animal alive.
Azithromycin (Not Recommended)
Cats: Azithromycin is not recommended therapy for feline hemoplasmosis.
Azithromycin, an azalide, is a subclass of macrolide antibiotics. When administered at a dose of 15 mg/kg PO twice a day for 7 days to cats experimentally infected with M haemofelis or Candidatus M haemominutum, azithromycin was not an effective treatment.11
Cats (particularly feral, stray, and flea-infested animals) can also be co-infected with Bartonella henselae. Based on in vitro testing, B henselae isolates rapidly developed azithromycin resistance due to a homogenous single nucleotide substitution in the 23S rRNA gene.12
Therapeutic elimination of hemotropic Mycoplasma spp infections can be challenging, and reactivation after treatment is not uncommon.
Closing Remarks
Although cats can be infected with Candidatus M haemominutum and Candidatus M turicensis, M haemofelis is considered the agent most likely to cause hemolytic anemia. Hemoplasmosis often occurs in association with immunosuppression or a concurrent infectious or noninfectious disease process.
Therapeutic elimination of hemotropic Mycoplasma spp infections can be challenging, and reactivation after treatment is not uncommon. Similar to cats, hemoplasmosis in dogs most often occurs as a result of concurrent disease or coinfection with a more pathogenic microorganism. Few experimental studies have evaluated therapy for canine hemotropic mycoplasmosis; based on limited follow-up polymerase chain reaction (PCR) assay data, as demonstrated in experimentally infected cats,10 dogs that recover from hemotropic mycoplasmosis probably have latent infections. The advent of PCR testing now allows clinicians to more accurately assess treatment efficacy for hemotropic Mycoplasma spp infections than was historically possible.13
DNA = deoxyribonucleic acid, mRNA = messenger ribonucleic acid, RNA = ribonucleic acid , tRNA = transfer ribonucleic acid, PCR = polymerase chain reaction, rRNA = ribosomal ribonucleic acid